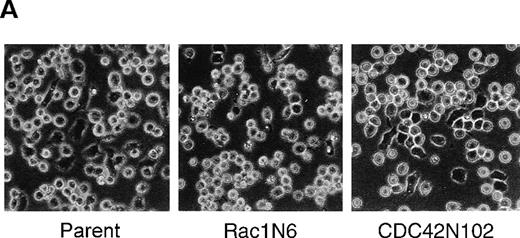
Fig. 4. Differential effects between N17Rac1 and N17CDC42 on the PMA-induced spreading on immobilized FN in BALL cells. / (A) Cells were cultured in 24-well plates coated with FN (10 μg/mL) in the absence or presence of PMA (100 ng/mL) for 12 hours. The morphology of the BALL cells was photographed by phase-contrast microscopy. Original magnification, × 200. (B) Spreading cells on FN in the presence of PMA were counted, and percentage spreading was calculated as described in “Materials and methods.” Data are mean ± SD of 3 independent experiments.

Abstract
Cell migration requires a dynamic interaction between the cell, its substrate, and the cytoskeleton-associated motile apparatus. Integrin-associated protein (IAP)/CD47 is a 50-kd cell surface protein that is physically associated with β3 integrins and that modulates the functions of β3 integrins in various cells. However, in B-lymphocytes that express β1 integrins but few β3 integrins, the roles of IAP/CD47 remain to be determined. Cross-linking of IAP/CD47 by the immobilized anti-IAP/CD47 monoclonal antibody (mAb) B6H12, but not 2D3, produced signals to promote polarization with lamellipodia, a characteristic morphology during leukocyte migration, in pre-B and mature B-cell lines (BALL, Nalm6, ONHL-1, Daudi), but not in myeloma cell lines (RPMI8226, OPM-2). In the presence of the immobilized fibronectin (FN), soluble B6H12 could increase the rate of the polarization and activate migratory activity of BALL cells to FN in a transwell filter assay. Furthermore, the dominant-negative form of CDC42 completely blocked B6H12-induced morphologic and functional changes without inhibiting phorbol 12-myristate 13-acetate–induced spreading on FN in BALL cells, whereas the dominant-negative form of Rac1 inhibited all these changes. These findings demonstrate that in B-lymphocytes, IAP/CD47 may transduce the signals to activate the migratory activity, in which CDC42 may be specifically involved, and that IAP/CD47 shows synergistic effect with 4β1 on B-cell migration. These findings would provide new insight into the role of IAP/CD47 on B-cell function.
Cell migration plays a key role in various biologic phenomena, including embryogenesis, wound healing, inflammation, and the immune response.1,2 Circulating leukocytes leave the bloodstream and enter inflammation sites across the endothelial cells, and circulating lymphocytes cross high endothelial venule (HEV) to enter lymphoid tissues,3,4 where lymphocytes migrate to interact with various cells for the differentiation of the cells responsible for the specific antigens.2 Cell migration requires a dynamic interaction between the cell, its substrate, and the cytoskeleton-associated motile apparatus. The initiation of cell locomotion involves a directional protrusion of the leading edge to form a lamellipodium, with its subsequent attachment to the substratum.5 It has been demonstrated that cell surface adhesion molecules have a central role in the migratory process.6 In peripheral lymph nodes, the interaction of L-selectin, with the peripheral node addressin expressed on HEV, is the first essential step in the extravasation of immunologically naive lymphocytes.7-9 This interaction mediates the tethering and rolling of lymphocytes in HEV, followed by β1 and β2 integrin-mediated adhesion and transmigration.6
Integrin-associated protein (IAP)/CD47 is a 50-kd cell surface glycoprotein with an extracellular immunoglobulin domain and 5 putative transmembrane domains10 that are widely expressed in various tissues.11 IAP/CD47 is physically associated with β3 integrins and the leukocyte response integrin that is immunologically related to the β3 integrin family,12,13 and it may regulate the functions of these integrins.12-14 Studies using neutrophils from gene-targeted mice deficient in IAP/CD47 and human neutrophils with anti-IAP/CD47 monoclonal antibodies (mAbs) indicated that IAP/CD47 plays a key role in β3 integrin-dependent ligand binding, activation of an oxidative burst, and Fc receptor-mediated phagocytosis.13,15 In addition, IAP/CD47−/− mice showed an early defect in neutrophil accumulation at the site of infection.15 In vitro, anti-IAP/CD47 mAb inhibited neutrophil migration across the endothelium and in colonic epithelial cells after firm adhesion.16 17
Although B-lymphocytes abundantly express IAP/CD47, its role in B-cell functions remains obscure. In the current study, using a range of B-cell lines, we show that anti-IAP/CD47 mAb B6H12, but not 2D3, in the immobilized form transduced the activating signals for locomotion in certain B-cell lines such as BALL cells. In transwell filter assays, IAP/CD47 showed a synergistic effect with α4β1 integrin on BALL-cell migration toward fibronectin (FN). Moreover, we show that the dominant-negative form of CDC42 specifically inhibited the increase in cell motile activity induced by anti-IAP/CD47 mAb. Our data demonstrate that IAP/CD47 mediates the signals regulating the motile activity in some B-cell lines and that CDC42 may be involved in this signaling pathway.
Materials and methods
Antibodies and reagents
Murine mAbs specific for CD49d/VLA-α4 (SG17, IgG2a), CD49e/VLA-α5 (ΚΗ72, IgG1), and CD29/VLA-β1 (SG19, IgG1) were generously provided by Dr K. Miyake (Saga Medical School, Saga, Japan).18 Integrin β1 subunit-specific mAb (8A2, IgG1), which is capable of activating β1 integrin, and integrin β3 subunit-specific mAb (AP3, IgG1) were generously provided by Dr J. Harlan (University of Washington, Seattle, WA)19 and Dr P. Newman (The Blood Center of Southeastern Wisconsin, Milwaukee, WI),20respectively. Monoclonal antibodies specific for integrin-associated protein (IAP)/CD47 (B6H12 and 2D3, IgG2b) were generously provided by Dr E. Brown (Washington University, St. Louis, MO).12 An integrin β2 subunit-specific mAb was purchased from Becton Dickinson (San Jose, CA). MOPC21 (IgG1) and MOPC195 (IgG2b) were purchased from Cappel Laboratories (Cochranville, PA). Hybridoma cells expressing the anti-myc mAb 9E10 were purchased from American Type Culture Collection (Rockville, MD). Human FN was purchased from Chemicon (Temecula, CA). Bovine serum albumin (BSA) (fraction V) and phorbol 12-myristate 13-acetate (PMA) were purchased from Sigma (St. Louis, MO). Pertussis toxin was generously provided by the Chemo-Sero Therapeutic Research Institute (Kumamoto, Japan).
Cell culture
Two human B-cell leukemia cell lines (BALL and Nalm6), a human lymphoma cell line (Daudi), and a human myeloma cell line (RPMI-8226) were obtained from the Japanese Cancer Research Resources Bank. Establishment and characterization of a human B-cell lymphoma cell line (ONHL-1) and a human myeloma cell line (OPM-2) were described previously.21 22 These cell lines were cultured in RPMI-1640 medium (GIBCO BRL, Grand Island, NY) supplemented with 10% fetal calf serum (Flow, Laboratories, North Ryde, Australia) at 37°C in the humidified atmosphere of 5% CO2.
Flow cytometry
The surface phenotypes of cells were examined by indirect immunofluorescence, as previously described.23 Briefly, cells were incubated with an appropriate mAb at 4°C for 30 minutes and then rinsed and developed with fluorescein isothiocyanate-conjugated goat antimouse IgG (Becton Dickinson).
Immobilization of fibronectin or monoclonal antibodies
Immobilization of FN or mAbs was performed as previously described.23 In brief, 96-well microtiter plates were coated with 50 μL FN solution (10 μg/mL) or 0.1% BSA solution at 37°C for 30 minutes and washed with phosphate-buffered saline (PBS). For blocking nonspecific binding sites, 96-well microtiter plates were further incubated with 50 μL 0.1% BSA solution at 37°C for 30 minutes. Wells were washed 3 times with PBS before cell culture. In some experiments, 96-well microtiter plates were coated with various mAbs (10 μg/mL) by the same procedure described above. Enzyme-linked immunosorbent assay showed that an equal amount of each mAb was coated on each well.
Stable transfection of dominant-negative Rac1 or CDC42
The pSRα-myc-tagged-N17Rac1 (myc-N17Rac1),-N17CDC42 (myc-N17CDC42), and pSRα-myc-tagged plasmid were generously provided by Drs K. Takaishi and Y. Takai (Osaka University, Osaka, Japan).24Transfection of pSRα-myc-tagged-N17Rac1,-myc-tagged-N17CDC42, or -myc-tagged plasmid to BALL cells was carried out using the electroporation method (960 μF, 0.25 kV) as previously described,25 and the transfected cells were isolated by the culture with G418 (Sigma) at the concentration of 1 mg/mL. Transfectedmyc-Rac1 or CDC42 protein was detected by the immunofluorescence studies described below and by immunoblotting with the 9E10 mAb.
Immunoblot assay
BALL cells transfected with each myc-tagged expression plasmid were lysed in a lysis buffer (1% NP-40, 50 mmol/L Tris-HCl, pH 8.0, 137 mmol/L NaCl, 5 mmol/L EDTA, 10% glycerol) containing protease inhibitors, and insoluble material was removed by centrifugation at 10,000g at 4°C for 10 minutes. Fifty micrograms cellular protein of each sample was subjected to 16% sodium dodecyl sulfate–polyacrylamide gel electrophoresis (SDS–PAGE), and separated proteins were electrophoretically transferred to polyvinylidene difluoride membrane (Hybond-P; Amersham). After blocking residual binding sites on the filter by incubation in Tris-buffered saline (10 mmol/L Tris-HCl, pH 8.0, 150 mmol/L NaCl) containing 1% BSA (Sigma) and 0.05% Tween 20 (Bio-Rad), immunoblotting was performed with 9E10 as a primary antibody by using the ECL detection kit (New England Nuclear, Dupont, MA).
Polarization assay
The polarization assay was performed as described by Komai–Koma et al with some modifications.26 Cells were washed with chemically defined medium (COS medium 004; Cosmobio, Tokyo, Japan), resuspended in COS medium 004 with 0.1% BSA, and incubated with either anti-IAP/CD47 mAb or isotype-matched mouse immunoglobulin at 4°C for 30 minutes. Aliquots of cell suspension (5 × 104cells) were inserted into 96-microtiter wells with FN. After 2 to 5 hours of incubation, the number of polarized cells with head-to-tail morphology was counted in the indicated area under phase-contrast microscopy. At least 300 cells/well were counted blindly, and the proportion of polarized cells was calculated according to the following formula: % polarization = (polarized cell number/total cell number) × 100. In some experiments, 96-microtiter wells were coated with anti-IAP/CD47 mAb or isotype-matched mouse IgG, and the polarization assay was performed as described above to investigate the roles of IAP/CD47 in human B-cell lines.
In selected experiments, BALL cells were also inserted into the 24-microtiter wells coated with 250 μL FN (10 μg/mL), in the presence or absence of 100 ng/mL PMA. In these experiments, BALL cells showed spreading rather than polarization in the presence of PMA. After 12 hours of incubation, the number of spreading (dark) cells was counted by phase-contrast microscopy, as described above.
Transmigration assays
For a direct measurement of migration, the transwell filter assay using modified Boyden chambers (Cell culture insert, 6.5-mm diameter, 8-μm pore size; Becton Dickinson) was performed, as described by Xia et al.27 Briefly, the undersides of polycarbonate membranes were coated with 50 μL FN solution at a concentration of 10 μg/mL at 37°C for 2 hours, rinsed once with PBS, and placed in the lower chamber containing 600 μL COS medium 004 with 0.1% BSA. Cells were washed 3 times with COS medium 004 and resuspended in COS medium 004 with 0.1% BSA (2 × 103/μL). After treatment with or without various mAbs at a concentration of 10 μg/mL at 4°C for 30 minutes, the aliquots (2 × 105 cells) of the cells were inserted into the upper chambers. After 24 hours of incubation at 37°C in 5% CO2, the inserts were shaken for 10 minutes at room temperature to detach the cells that adhered to the undersides of the filters, and the number of cells was counted in the lower chamber. The filters were fixed with 100% methanol, and the nonmigrated cells in the upper chamber were removed with a cotton swab. After that, the filters were stained with May–Grünwald–Giemsa solution to confirm that no adherent cells remained on the undersides.
Adhesion assays
To measure adhesion activity to FN, adhesion assays using a crystal violet method were performed as previously reported.28 Briefly, 1 × 105 cells with or without preincubation by various mAbs in COS medium 004 were applied to 96-microtiter plate wells prepared as described in “Polarization Assays.” After washing the wells 3 times with COS medium 004, adherent cells were fixed with 1% glutaraldehyde in PBS for 15 minutes and stained with 0.1% crystal violet solution for 30 minutes. After destaining by distilled water for 15 minutes, the dyes were solubilized with 200 μL distilled water containing 0.2% Triton-X100, and then the absorbance at 620 nm was measured by microphotometry.
FN binding assay
The binding assay using sodium iodide I 125-labeled FN was performed as previously described.29 Briefly, the cells were washed 3 times with COS medium 004 and resuspended in COS medium 004 at a cell density of 1 × 104/μL. After preincubation of the cells with various mAbs at a concentration of 20 μg/mL at 4°C for 30 minutes, the aliquots of cell suspension (1 × 106cells) were incubated with 125I-labeled FN at a concentration of 10 μg/mL at 37°C for 1 hour. Then the cells were sedimented through 30% sucrose by centrifugation for 10 minutes at 10,000g. Radioactivity levels of cell-bound125I-labeled FN were counted on a γ counter.
Immunofluorescence microscopy
Cell-culture chamber slides (4 chamber, Becton Dickinson) were coated with anti-IAP/CD47 mAb or isotype-matched mouse IgG as described above. Cells (2 × 105) that had been suspended in COS medium 004 were added to the chamber and incubated for 5 hours. Cells were fixed with 4% paraformaldehyde for 15 minutes, incubated with 50 mmol/L NH4Cl in PBS for 10 minutes, and permeabilized with 0.2% Triton X-100 for 10 minutes. After a 1-hour incubation with PBS containing 3% fetal calf serum, the cells were incubated with biotinylated 9E10 in PBS containing 0.2% BSA (5 μg/mL) for 2 hours. After they were washed with PBS containing 0.2% BSA, the cells were incubated with isothiocyanate-conjugated fluorescein avidin (Sigma) for 1 hour. Finally, for visualization of the nucleus, the cells were incubated with 4′6-diamino-2-phenylindole dihydrochloride (DAPI) solution. After they were washed in PBS, the cells were photographed through a fluorescence microscope. To examine changes in the actin fibers, the cells, prepared as described above, were incubated with rhodamine-conjugated phalloidin (Sigma) for 1 hour. After incubation with DAPI, the cells were examined and photographed through a microscope.
Results
Expression of integrins and IAP/CD47 on human B-cell lines
We first examined the expression of integrin β subunits and IAP/CD47 on various human B-cell lines. As shown in Table 1, all the cell lines examined in this study abundantly expressed IAP/CD47. The β1 subunit was expressed in all cell lines, whereas the β3 subunit, which could be associated with IAP/CD47, was weakly expressed in only OPM-2 cells but in few other cell lines. Concerning FN receptors, all B-cell lines highly expressed α4β1 (very late antigen [VLA]-4), but—except for Nalm6—only small amounts of α5β1 (VLA-5) were expressed in these cell lines.
Table. Expression of β integrins and IAP/CD47 on human B cell lines
| Stage . | Cell line . | Expression (%) . | |||||
|---|---|---|---|---|---|---|---|
| α4 . | α5 . | β1 . | β2 . | β3 . | IAP/CD47 . | ||
| Pre-B | BALL | 97.6 | 1.5 | 99.3 | 55.2 | 0.3 | 98.7 |
| Nalm6 | 92.1 | 91.5 | 92.9 | 0.1 | 0 | 93.4 | |
| Mature | ONHL-1 | 84.2 | 1.8 | 89.4 | 96.3 | 4.0 | 99.1 |
| Daudi | 66.7 | 0.6 | 76.5 | 3.9 | 0 | 78.6 | |
| Plasma | RPMI8226 | 66.2 | 6.2 | 78.5 | 0.1 | 0 | 95.8 |
| OPM2 | 90.1 | 1.9 | 97.3 | 20.2 | 23.8 | 99.2 | |
| Stage . | Cell line . | Expression (%) . | |||||
|---|---|---|---|---|---|---|---|
| α4 . | α5 . | β1 . | β2 . | β3 . | IAP/CD47 . | ||
| Pre-B | BALL | 97.6 | 1.5 | 99.3 | 55.2 | 0.3 | 98.7 |
| Nalm6 | 92.1 | 91.5 | 92.9 | 0.1 | 0 | 93.4 | |
| Mature | ONHL-1 | 84.2 | 1.8 | 89.4 | 96.3 | 4.0 | 99.1 |
| Daudi | 66.7 | 0.6 | 76.5 | 3.9 | 0 | 78.6 | |
| Plasma | RPMI8226 | 66.2 | 6.2 | 78.5 | 0.1 | 0 | 95.8 |
| OPM2 | 90.1 | 1.9 | 97.3 | 20.2 | 23.8 | 99.2 | |
Data are expressed as the mean of three independent experiments.
Immobilized anti-IAP/CD47 mAb induces polarized shape change in human B-cell lines
To investigate the roles of IAP/CD47 in human B cells, we examined the effect of immobilized anti-IAP/CD47 mAbs, B6H12 and 2D3, on human B cell lines. Cells were cultured for 12 hours on wells coated with equal amounts of each anti-IAP/CD47 mAb in a serum-free condition. B6H12 induced an elongated and polarized shape change (polarization), which has been shown to accompany and to be necessary for the locomotion of lymphocytes (Figure 1A). In 2 pre-B cell lines (BALL and Nalm6) and 2 lymphoma cell lines (ONHL-1 and Daudi), the polarized shape change induced by immobilized B6H12 was prominently observed, although 2 myeloma cell lines (RPMI8226 and OPM-2) did not respond to the immobilized B6H12 (Figure 1B). In contrast, neither soluble B6H12 (see Figure 5A) nor immobilized 2D3 significantly induced polarization in any of the cell lines. Time-course observation showed that this morphologic change appeared from 1 to 2 hours and that the rate of the polarization reached the maximal level from 5 to 6 hours after incubation (Figure3B). Although the cells reacted with the immobilized B6H12 underwent dynamic changes in morphology—from round to polarized and from polarized to round at intervals of several minutes—the cells stayed at the same place rather than migrate randomly (data not shown). These findings suggested that immobilized B6H12, but not 2D3, induces intracellular signals by IAP/CD47, leading to polarization in human B-cell lines.
Immobilized anti-IAP/CD47 mAb (B6H12) induces the polarization in human B cell lines.
(A) Phase-contrast micrographs of BALL cells on immobilized anti-IAP/CD47 mAbs. BALL cells were cultured on the plates coated with each mAb (10 μg/mL) for 5 hours. Immobilized B6H12 could induce the elongated and head–tail morphology (polarization) in BALL cells. (B6H12, 2D3: anti-IAP/CD47 mAb; MOPC195: mouse IgG2b). Initial magnification, × 400. (B) The rate of polarization induced by the immobilized B6H12 in human B-cell lines. Cells were cultured on the plates immobilized with B6H12, and the rate of polarization was calculated as described in “Materials and Methods.” In 2 pre-B cell lines (BALL and Nalm6) and 2 lymphoma cell lines (ONHL-1 and Daudi), the polarization on the immobilized B6H12 was prominently observed. Data are shown as the mean ± SD in 3 independent experiments.
Immobilized anti-IAP/CD47 mAb (B6H12) induces the polarization in human B cell lines.
(A) Phase-contrast micrographs of BALL cells on immobilized anti-IAP/CD47 mAbs. BALL cells were cultured on the plates coated with each mAb (10 μg/mL) for 5 hours. Immobilized B6H12 could induce the elongated and head–tail morphology (polarization) in BALL cells. (B6H12, 2D3: anti-IAP/CD47 mAb; MOPC195: mouse IgG2b). Initial magnification, × 400. (B) The rate of polarization induced by the immobilized B6H12 in human B-cell lines. Cells were cultured on the plates immobilized with B6H12, and the rate of polarization was calculated as described in “Materials and Methods.” In 2 pre-B cell lines (BALL and Nalm6) and 2 lymphoma cell lines (ONHL-1 and Daudi), the polarization on the immobilized B6H12 was prominently observed. Data are shown as the mean ± SD in 3 independent experiments.
Pertussis toxin has no inhibitory effect on the polarization induced by the immobilized B6H12
Because it has been suggested that IAP/CD47 functionally couples to heterotrimeric Gi protein in a number of cell types,30 we examined the effect of pertussis toxin (PT) on the immobilized B6H12-induced polarization in BALL cells. The activity of PT was confirmed by Chinese hamster ovary cell cytotoxicity assay.31 However, PT exhibited no inhibitory effect on the B6H12-induced polarization (% polarization: 36.4 ± 2.6 in the absence of PT; 38.5 ± 0.7 in the presence of 1.0 μg/mL PT; n = 3). These data suggested that heterotrimeric Gi is not involved in the polarization induced by B6H12 through IAP/CD47, at least in B cell lines.
Rac1 and CDC42 play important roles in the signals to induce polarization through IAP/CD47 in BALL cells
To analyze the changes in cell morphology and cytoskeletal reorganization initiated by the immobilized B6H12 by IAP/CD47, the BALL cells were stained with rhodamine-conjugated phalloidin. In the polarized cells on the immobilized B6H12, F-actin accumulated at the anterior veil or “lamellipodium” (Figure2). In contrast, F-actin was still diffusely distributed in the cytoplasm in the BALL cells plated on the immobilized 2D3 (data not shown). Because members of Rho family, such as Rac1 and CDC42, have been shown to play important roles in the cytoskeletal reorganization and activation of leukocytes, we then investigated the roles of these molecules in the polarization of BALL cells induced by B6H12 through IAP/CD47. The pSRαneo expression plasmid containing a dominant-negative form of either myc-Rac1 (N17Rac1) or myc-CDC42 (N17CDC42) was transfected to BALL cells, and cell clones were isolated by resistance to G418. As shown in Figures 2 and 3, the expression of N17Rac1 or N17CDC42 was confirmed by immunoblotting and immunofluorescence staining by anti-myc mAb 9E10. Under phase-contrast microscopy, most of the N17Rac1- or N17CDC42-transfected BALL cells still were round after incubation of the immobilized B6H12, as observed in parent cells on the isotype-matched mAb MOPC195, whereas pSRα (vector)-transfected cells clearly showed the polarization (Figures 2 and 3). In N17Rac1-transfected cells, immunofluorescence staining with phalloidin showed that the reorganization of F-actin was induced, but did not localized, in the periphery of the cell. By contrast, in N17CDC42-transfected BALL cells, F-actin localized in the periphery of the cell. However, the formation of lamellipodia or filopodia was not induced in both cells. Time-course analysis showed that both N17Rac1 and N17CDC42 inhibited the polarization induced by the immobilized B6H12 at any time examined and that the inhibitory effect of N17CDC42 was more predominant (Figure 3). These data suggest that a different action between Rac1 and CDC42 on cytoskeletal reorganization.
Phase-contrast microscopy and immunofluorescence staining of BALL cells that express either N17Rac1 or N17CDC42.
Cells were cultured on the culture slide coated with either MOPC195 or B6H12 (10 μg/mL) for 5 hours. The morphology of the BALL cells was photographed under phase-contrast microscopy. For immunofluorescence staining, the cells were fixed and stained with either anti-mycmAb 9E10 or phalloidin, as described in “Materials and methods.” (A-C) Phase-contrast micrograph in the incubation on immobilized B6H12. (D-F) Immunofluorescence staining with phalloidin on immobilized B6H12. (G-I) Immunofluorescence staining with 9E10 on B6H12. (A, D, G) Vector. (B, E, H) N17Rac1N6. (C, F, I) N17CDC42N102. Initial magnifications, × 400 in A-C and × 1000 in D-I.
Phase-contrast microscopy and immunofluorescence staining of BALL cells that express either N17Rac1 or N17CDC42.
Cells were cultured on the culture slide coated with either MOPC195 or B6H12 (10 μg/mL) for 5 hours. The morphology of the BALL cells was photographed under phase-contrast microscopy. For immunofluorescence staining, the cells were fixed and stained with either anti-mycmAb 9E10 or phalloidin, as described in “Materials and methods.” (A-C) Phase-contrast micrograph in the incubation on immobilized B6H12. (D-F) Immunofluorescence staining with phalloidin on immobilized B6H12. (G-I) Immunofluorescence staining with 9E10 on B6H12. (A, D, G) Vector. (B, E, H) N17Rac1N6. (C, F, I) N17CDC42N102. Initial magnifications, × 400 in A-C and × 1000 in D-I.
Dominant-negative forms of Rac1 and CDC42 significantly suppress the B6H12-induced polarization in BALL cells.
(A) The stable clones expressing either N17Rac1 (N2, N4, and N6) or N17Cdc42 (N2, N9, and N102) were obtained as described in “Materials and methods.” After the incubation on the immobilized B6H12 (10 μg/mL) for 5 hours, the rate of polarization of each clone was calculated. Data are shown as mean ± SD in 3 independent experiments. Data of immunoblotting using anti-myc mAb 9E10 in each whole-cell lysate are shown in the lower panel. (B) Time-course analysis of the B6H12-induced polarization of N17Rac1- and N17CDC42- transfected BALL cells. Representative data are shown as mean ± SD in 3 independent experiments. Two other independent experiments showed similar results. Open circle, parent. Closed circle, vector. Square, N17Rac1N6. Triangle, N17CDC42. Other clones showed similar results.
Dominant-negative forms of Rac1 and CDC42 significantly suppress the B6H12-induced polarization in BALL cells.
(A) The stable clones expressing either N17Rac1 (N2, N4, and N6) or N17Cdc42 (N2, N9, and N102) were obtained as described in “Materials and methods.” After the incubation on the immobilized B6H12 (10 μg/mL) for 5 hours, the rate of polarization of each clone was calculated. Data are shown as mean ± SD in 3 independent experiments. Data of immunoblotting using anti-myc mAb 9E10 in each whole-cell lysate are shown in the lower panel. (B) Time-course analysis of the B6H12-induced polarization of N17Rac1- and N17CDC42- transfected BALL cells. Representative data are shown as mean ± SD in 3 independent experiments. Two other independent experiments showed similar results. Open circle, parent. Closed circle, vector. Square, N17Rac1N6. Triangle, N17CDC42. Other clones showed similar results.
To test whether Rac1 and CDC42 may be specifically involved in the signaling through IAP/CD47, we examined the effect of the dominant negative form of Rac1 and CDC42 on PMA-induced spreading of BALL cells on the immobilized FN. As shown in Figure4, PMA-activated cells showed spreading rather than polarization on immobilized FN. N17Rac1 significantly decreased the number of spreading of BALL cells on FN induced by PMA, whereas N17CDC42 did not suppress the BALL cell spreading on FN. These results suggested that CDC42 is more specifically involved in the signals to induce polarization through IAP/CD47 in BALL cells than Rac1.
Differential effects between N17Rac1 and N17CDC42 on the PMA-induced spreading on immobilized FN in BALL cells.
(A) Cells were cultured in 24-well plates coated with FN (10 μg/mL) in the absence or presence of PMA (100 ng/mL) for 12 hours. The morphology of the BALL cells was photographed by phase-contrast microscopy. Original magnification, × 200. (B) Spreading cells on FN in the presence of PMA were counted, and percentage spreading was calculated as described in “Materials and methods.” Data are mean ± SD of 3 independent experiments.
Differential effects between N17Rac1 and N17CDC42 on the PMA-induced spreading on immobilized FN in BALL cells.
(A) Cells were cultured in 24-well plates coated with FN (10 μg/mL) in the absence or presence of PMA (100 ng/mL) for 12 hours. The morphology of the BALL cells was photographed by phase-contrast microscopy. Original magnification, × 200. (B) Spreading cells on FN in the presence of PMA were counted, and percentage spreading was calculated as described in “Materials and methods.” Data are mean ± SD of 3 independent experiments.
Soluble anti-IAP/CD47 mAb enhances migratory activity of BALL cells
In contrast to the immobilized B6H12, its soluble form failed to augment the polarization of BALL cells. Although BALL cells expressed α4β1 (VLA-4) but little α5β1 (VLA-5) as an FN receptor, immobilized FN did not augment the polarization. However, soluble B6H12 in the presence of immobilized FN markedly increased the rate of the polarization of BALL cells (Figure 5A). This augmentation was markedly inhibited by the anti-β1 mAb, SG19 (% inhibition: 61.2 ± 1.4) (Figure 5B). Again, soluble 2D3 and MOPC195 failed to increase the polarization on immobilized FN (% polarization: 18.1 ± 3.7 for 2D3 and 16.9 ± 31.4 for MOPC195). Because thrombospondin (TSP) or its functional peptide, 4N1K, has been shown to induce cell spreading and migration through IAP/CD47,32 33 we examined the effect of 4N1K peptide instead of the soluble B6H12. However, 4N1K did not increase the polarization of BALL cells on FN. These data suggest that soluble B6H12 has synergistic effects with immobilized FN on the polarization of BALL cells.
Anti-IAP/CD47 mAb (B6H12) promotes the migration to FN through 4β1 (VLA-4) in BALL cells.
(A) After the preincubation of B6H12 (10 μg/mL) at 4°C for 30 minutes, the BALL cells (5 × 104) were incubated on the 96-microtiter wells coated with FN (10 μg/mL) in the presence of soluble B6H12. After 2 hours of incubation, the rate of polarized cells was counted. (B) Polarization assay was performed in the presence or absence of anti-β1 mAb (SG19), as described in A. Data are shown mean ± SD of 3 independent experiments. (C) After preincubation of anti-IAP/CD47 mAbs as described above, the cells (1 × 105) were applied into the cell culture insert prepared as described in “Materials and methods.” After 24 hours of incubation, cells that transmigrated to the lower chamber were counted. (2D3, B6H12; anti-IAP/CD47, MOPC195; mouse IgG2b). Representative data are shown from 3 independent experiments. (D) The transmigration assay using Boyden chamber was performed in the presence or absence of anti-β1 mAb (SG19), as described in C. Data are shown mean ± SD of 3 independent experiments. Statistically significant differences from control values are indicated by *P < .01. Percentage inhibition was calculated as the following formula: % inhibition = [(% transmigration with B6H12 − % transmigration with B6H12 and SG19)/(% transmigration with B6H12 − % transmigration with MOPC21)] × 100.
Anti-IAP/CD47 mAb (B6H12) promotes the migration to FN through 4β1 (VLA-4) in BALL cells.
(A) After the preincubation of B6H12 (10 μg/mL) at 4°C for 30 minutes, the BALL cells (5 × 104) were incubated on the 96-microtiter wells coated with FN (10 μg/mL) in the presence of soluble B6H12. After 2 hours of incubation, the rate of polarized cells was counted. (B) Polarization assay was performed in the presence or absence of anti-β1 mAb (SG19), as described in A. Data are shown mean ± SD of 3 independent experiments. (C) After preincubation of anti-IAP/CD47 mAbs as described above, the cells (1 × 105) were applied into the cell culture insert prepared as described in “Materials and methods.” After 24 hours of incubation, cells that transmigrated to the lower chamber were counted. (2D3, B6H12; anti-IAP/CD47, MOPC195; mouse IgG2b). Representative data are shown from 3 independent experiments. (D) The transmigration assay using Boyden chamber was performed in the presence or absence of anti-β1 mAb (SG19), as described in C. Data are shown mean ± SD of 3 independent experiments. Statistically significant differences from control values are indicated by *P < .01. Percentage inhibition was calculated as the following formula: % inhibition = [(% transmigration with B6H12 − % transmigration with B6H12 and SG19)/(% transmigration with B6H12 − % transmigration with MOPC21)] × 100.
To examine directly the effects of soluble B6H12 on the migratory activity of BALL cells in the presence of immobilized FN, we next performed the transmigration assay using a modified Boyden chamber in which undersides of membranes were coated with FN. In the transmigration assay, FN alone did not increase the transmigration of BALL cells (data not shown). However, addition of the soluble form of B6H12 increased the migratory activity of BALL cells to immobilized FN approximately 2-fold, whereas neither 2D3 nor isotype-matched IgG affected the migratory activity of BALL cells to FN (Figure 5C). SG19 again markedly suppressed the increase in the transmigration to FN (% inhibition: 62.2 ± 5.4) (Figure 5D). As shown in Figure6, soluble B6H12 did not change the adhesion of BALL cells to FN or the soluble FN binding to BALL cells, but 8A2, an activating mAb against β1 integrin, increased the cell adhesion and the FN binding. As expected, the increase of the cell adhesion to FN by 8A2 was inhibited by anti-α4 mAb (SG17) but not anti-α5 mAb (KH72), which indicates that BALL cell adhesion to FN is mediated by α4β1 (data not shown). However, 8A2 could not induce the polarization on FN in BALL cells (data not shown). These results suggested that soluble B6H12 has synergistic effect with FN on the migratory activity without affecting to the activation state of β1 integrin.
Anti-IAP/CD47 mAb (B6H12) does not change the avidity/affinity of 4β1 (VLA-4) in BALL cells.
(A) Adhesion assay using the crystal violet method was performed as described in “Materials and methods.” B6H12 did not affect the adhesion to FN, whereas 8A2, an activating mAb against β1 integrin, significantly promoted the adhesion to FN. (B) The binding of FN to BALL cells was performed as described in “Materials and methods.” B6H12 had no effect on the FN binding to BALL cells. Data are mean ± SD of 3 independent experiments. Statistically significant differences from control values are indicated by *P < .01.
Anti-IAP/CD47 mAb (B6H12) does not change the avidity/affinity of 4β1 (VLA-4) in BALL cells.
(A) Adhesion assay using the crystal violet method was performed as described in “Materials and methods.” B6H12 did not affect the adhesion to FN, whereas 8A2, an activating mAb against β1 integrin, significantly promoted the adhesion to FN. (B) The binding of FN to BALL cells was performed as described in “Materials and methods.” B6H12 had no effect on the FN binding to BALL cells. Data are mean ± SD of 3 independent experiments. Statistically significant differences from control values are indicated by *P < .01.
N17Rac1 and N17CDC42 inhibited the B6H12-induced migration to FN in BALL cells
We examined the role of Rac1 and CDC42 on the soluble B6H12-induced increase in the polarization and the migration of BALL cells in the presence of FN. In the polarization assay on FN, the increase in the rate of polarized cells was completely blocked in both N17Rac1- and N17CDC42-transfected cells (N17Rac1N6 and N17CDC42N102, respectively) (Figure 7A). Similarly, the transmigration assay showed that B6H12 could not increase the transmigration of either N17Rac1- or N17CDC42-transfected BALL cells to FN (Figure 7B). On the other hand, flow cytometric analysis showed that none of the expression of α4β1, α5β1, or IAP/CD47 on the cell surface of all clones was changed by the transfection of N17Rac1, N17CDC42, ormyc-tagged pSRα (data not shown). We also examined whether cell adhesion to the immobilized FN and FN binding to the cells might be modified in these transfectants. Neither N17Rac1 nor N17CDC42 affected the adhesion of BALL cells to FN, even after the activation of β1 integrins by 8A2 (Figure 7C). These data suggest that neither Rac1 nor CDC42 is involved in BALL cell adhesion to FN through α4β1 integrin, even in the high-affinity/avidity state. Similarly, FN binding assay showed that neither N17Rac1 nor N17CDC42 affected the ligand-binding activity, whereas 8A2 could promote the binding of FN to BALL cells (Figure 7D). These results suggested that both N17Rac1 and N17CDC42 play important roles in the signals through IAP/CD47 that increase cell motility of BALL cells.
Dominant-negative form of Rac1 and CDC42 inhibits the B6H12-induced transmigration on FN without affecting the avidity/affinity of 4β1 (VLA-4).
The polarization assay on the immobilized FN (A) and the transmigration assay to FN (B) were performed in the presence of the indicated mAb (10 μg/mL) in each stable clone, as described in “Materials and methods.” The adhesion assay using crystal violet method (C) and the FN binding assay (D) in the presence of the indicated mAb in each stable clone were performed, as described in “Materials and methods.” Data are mean ± SD of 3 independent experiments. Statistically significant differences from control values are indicated by *P < .01 and **P < .05. Solid bars, vector. Open bars, N17Rac1N6. Hatched bars, N17CDC42N102.
Dominant-negative form of Rac1 and CDC42 inhibits the B6H12-induced transmigration on FN without affecting the avidity/affinity of 4β1 (VLA-4).
The polarization assay on the immobilized FN (A) and the transmigration assay to FN (B) were performed in the presence of the indicated mAb (10 μg/mL) in each stable clone, as described in “Materials and methods.” The adhesion assay using crystal violet method (C) and the FN binding assay (D) in the presence of the indicated mAb in each stable clone were performed, as described in “Materials and methods.” Data are mean ± SD of 3 independent experiments. Statistically significant differences from control values are indicated by *P < .01 and **P < .05. Solid bars, vector. Open bars, N17Rac1N6. Hatched bars, N17CDC42N102.
Discussion
In this study, we have investigated the role of IAP/CD47 on human B-cell lines. Cross-linking of IAP/CD47 by the immobilized B6H12 is sufficient to produce signals to promote polarization with lamellipodia in pre-B and mature B cell lines (BALL, Nalm6, ONHL-1, Daudi), but not in myeloma cell lines (RPMI8226, OPM-2). Neither the immobilized 2D3 nor the soluble B6H12 increased the rate of polarization. These findings are consistent with those previously reported in neutrophils and T lymphocytes that B6H12, but not 2D3, recognizes functionally important regions of IAP/CD47.13,16 34 In the presence of the immobilized FN, soluble B6H12 could increase the rate of polarization and activate migratory activity to FN in BALL cells. The dominant-negative form of CDC42 completely blocked B6H12-induced morphologic and functional changes without inhibiting PMA-induced cell spreading on FN in BALL cells, whereas N17Rac1 inhibited all these changes. These findings indicate that IAP/CD47 transduces the signals to promote the migratory activity in certain human B-cell lines and that CDC42 rather than Rac1 may be involved in this signal transduction pathway.
In B-lymphocytes, cell migration is an essential process for recirculating blood and lymphoid tissues and to differentiate into the cells responsible for specific antigen. The interaction of L-selectin with the peripheral node addressin expressed on HEV mediates the tethering and rolling of lymphocytes in HEV, followed by β1 and β2 integrin-mediated adhesion and transmigration.2-4 Indeed BALL cells, which grow in suspension, were not induced by polarization, lamellipodia, or migratory activity in the transwell assay by immobilized FN. The failure of the induction of polarization or lamellipodia was not caused by a low-affinity/avidity state of α4β1 because the induction of high-affinity/avidity state of α4β1 by 8A2 still failed to induce polarization. In addition, neither the dominant-negative form of Rac1 nor CDC42 affected BALL cell adhesion to FN. In sharp contrast to fibroblasts,35,36 these data demonstrate that the interaction of α4β1 with FN is insufficient to induce morphologic changes such as lamellipodia and that neither Rac1 nor CDC42 is involved in cell adhesion to FN in BALL cells. However, the addition of soluble B6H12 induced polarization on BALL cells attached to FN. Moreover, in the transwell assay, soluble B6H12 augmented BALL cell transmigration to FN. These changes were partially blocked by SG19. It has been reported that the expression and the function of integrins and ligand intensity affect the migratory activity mediated by integrins of the cells.37 However, the cell adhesion assay and the FN binding assay revealed that B6H12 did not affect the affinity/avidity of α4β1 in BALL cells. These data indicate the possibility that soluble B6H12 may have a synergistic effect with FN on the migratory activity by modulating the signals through α4β1 rather than by affecting the activation state of β1 integrin. Besides the regulation of β3 integrin functions, Wang et al12-14 showed that IAP/CD47 can modulate the signals through α2β1 (VLA-2) for the migration to collagen in aortic smooth muscle cells.32 We here show another example for the modulation of β1 integrin (α4β1) by IAP/CD47 in B lymphocytes.
B6H12 promotes the CD3-mediated proliferation and IL-2 secretion as a co-stimulatory signal in T-lymphocytes34,38 and activates oxidative burst as a signal transduction unit with leukocyte response integrin in neutrophils.13 These effects were observed only when B6H12 was immobilized, and soluble B6H12 showed no effects or even inhibitory effects. In contrast, the immobilization of B6H12 by itself is sufficient to induce polarization without any additional signals in certain human B-cell lines, and soluble B6H12 promoted the migration of BALL cells to the immobilized FN. These data suggest that IAP/CD47 is a signaling molecule to regulate motility in human B-cell lines. The polarized shape change was predominantly induced in 2 pre-B cell lines (BALL and Nalm6) and 2 lymphoma cell lines (ONHL-1 and Daudi) by the immobilized B6H12, but not in 2 myeloma cell lines (RPMI8226 and OPM-2). Although only a limited number of B-cell lines was tested in this study, our results are consistent with findings that B-lymphocytes, but not plasma cells, recirculate at an early stage between bone marrow and lymphoid tissues, and they suggest that the role of IAP/CD47 in migration would change during the differentiation of B-lymphocytes.
Thrombospondin (TSP) is a ligand for IAP/CD47, and TSP or its peptide stimulates integrin-mediated function such as cell spreading,33 cell migration,32 and platelet aggregation.39 Moreover, it has been shown that pertussis toxin-sensitive heterotrimeric guanosine triphosphate-binding protein (G protein) is involved in the signals to stimulate the cytoskeletal reorganization through the interaction between IAP/CD47 and TSP in melanoma cells.33,40 Frazier et al30 recently demonstrated the functional coupling of IAP/CD47 to heterotrimeric Gi. However, pertussis toxin could not inhibit the B6H12-induced polarization on immobilized FN. Our results led to the speculation that a different mechanism, in which heterotrimeric G protein is not involved, would exist in the signals through IAP/CD47 induced by B6H12 in B cells. In contrast to B6H12, the functional peptide (4N1K) from TSP had no significant effect on the polarization and migration in this study. One possible explanation is that the cross-linking of IAP/CD47 might be necessary for signal transduction. Because G protein is not involved in the signaling induced by B6H12, it is also possible that ligands for IAP/CD47 other than TSP might be involved in the signaling. In addition to TSP, SHPS-1 has been identified as a ligand for IAP/CD4741 and has been reported to play important roles in the interaction between monocytes and T cells and the activation of macrophages.42,43 In addition, the interaction between these antigen-presenting cells and B cells are essential to the development of antibody responses.44 45 The roles of SHPS-1 as a ligand for IAP/CD47 in human B cells are currently under investigation.
The members of small GTPases of Rho family play important roles in the signaling processes through integrins and cytoskeletal organization.35,36,46-49 Several studies using the dominant-negative form of Rho family (RhoA, Rac1, and CDC42) have shown that the members of the Rho family and their effectors are involved in cytoskeletal reorganization, such as lamellipodia and filopodia.24,50-53 In addition, the constitutively active form of Rac1 induced cell spreading on FN in the Jurkat cell line.54 Overexpression of Tiam1 (an activator of Rac1), or constitutively active form of Rho family (Rac1 or CDC42) induced invasion of murine T-lymphoma cells to fibroblast monolayer.55 56 The induction of lamellipodia by B6H12 suggests that Rho family GTPase may be involved in the signaling pathway through IAP/CD47. To examine further the signaling pathway, we established stable transfectants of BALL cells that expressed the dominant-negative form of either Rac1 or CDC42. The dominant-negative form of Rac1 and CDC42 blocked the polarization induced by the immobilized B6H12. Moreover, the dominant-negative form of Rac1 and CDC42 abolished the B6H12-induced migration to FN without affecting the activation state of α4β1.
Hierarchical regulation and differential function among Rho family GTPases have been reported in fibroblasts and leukocytes.49-52 In BALL cells, there are some differences between N17Rac1- and N17CDC42-transfected cells in the cytoskeletal reorganization induced by the immobilized B6H12. In N17CDC42-transfected BALL cells, F-actin accumulated to the cell periphery, whereas there was no apparent localization in N17Rac1-transfected cells. In addition, N17Rac1 suppressed PMA-induced spreading on FN, whereas N17CDC42 did not. These results indicate that Rac1 and CDC42 have differential roles in cytoskeletal reorganization in BALL cells. Moreover, it is suggested that CDC42 is more specifically involved than Rac1 in the signals through IAP/CD47 to induce the motile activities. Further studies concerning the functional roles and the signal transduction pathway of IAP/CD47 would add great value to the understanding of the mechanisms of immune responses in B cells.
Acknowledgments
We thank Dr K. Miyake for providing the mAbs SG17, KH72, and SG19, Dr J. Harlan for 8A2, Dr P. Newman for AP3, and Dr E. Brown for B6H12 and 2D3. We thank Drs K. Takaishi and Y. Takai for providing the pSRα-myc-tagged-N17Rac1 (myc-N17Rac1), pSRα-myc-tagged-N17CDC42 (myc-N17CDC42), and pSRα-myc-tagged plasmid. We thank the Chemo-Sero Therapeutic Research Institute for providing pertussis toxin. We also thank Drs Y. Murayama and K. Yamamoto for technical advice on the immunofluorescence microscopy.
Supported in part by a grant from the Ministry of Education, Science, and Culture of Japan, Tokyo; and the Japan Society for the Promotion of Science, Tokyo; and Senri Life Science Foundation, Osaka, Japan.
Reprints:Yoshiaki Tomiyama, Department of Internal Medicine and Molecular Science, Osaka University, Graduate School of Medicine, 2-2 Yamada-oka, Suita, 565-0871, Japan.
The publication costs of this article were defrayed in part by page charge payment. Therefore, and solely to indicate this fact, this article is hereby marked “advertisement” in accordance with 18 U.S.C. section 1734.

![Fig. 5. Anti-IAP/CD47 mAb (B6H12) promotes the migration to FN through 4β1 (VLA-4) in BALL cells. / (A) After the preincubation of B6H12 (10 μg/mL) at 4°C for 30 minutes, the BALL cells (5 × 104) were incubated on the 96-microtiter wells coated with FN (10 μg/mL) in the presence of soluble B6H12. After 2 hours of incubation, the rate of polarized cells was counted. (B) Polarization assay was performed in the presence or absence of anti-β1 mAb (SG19), as described in A. Data are shown mean ± SD of 3 independent experiments. (C) After preincubation of anti-IAP/CD47 mAbs as described above, the cells (1 × 105) were applied into the cell culture insert prepared as described in “Materials and methods.” After 24 hours of incubation, cells that transmigrated to the lower chamber were counted. (2D3, B6H12; anti-IAP/CD47, MOPC195; mouse IgG2b). Representative data are shown from 3 independent experiments. (D) The transmigration assay using Boyden chamber was performed in the presence or absence of anti-β1 mAb (SG19), as described in C. Data are shown mean ± SD of 3 independent experiments. Statistically significant differences from control values are indicated by *P < .01. Percentage inhibition was calculated as the following formula: % inhibition = [(% transmigration with B6H12 − % transmigration with B6H12 and SG19)/(% transmigration with B6H12 − % transmigration with MOPC21)] × 100.](https://ash.silverchair-cdn.com/ash/content_public/journal/blood/96/1/10.1182_blood.v96.1.234/4/m_bloo01306005x.jpeg?Expires=1771327905&Signature=TcTXNz2GU9xsqvKVxXJ137U-gapQS3oCGVd3HPXfsNoDCF-5oK3Bia8Ng5daJdFFbm7l4qguub95S91An6goUXiWPCowAhxqq9S6i9NG4PvwyOWKUdfqsRpg1fI7waXcugXcQsyospyveUOzWgsjNjhZXli3OdN6wzLBFy6WZG2yisv0XFc7GUsR-BOZdvwT9Px1VOiMOAvhts~UQ1AM7jqSs0TaD595d0qdRr2l8MqhypJDnrah2Ac4pf1jIKyr49xT0Z-AzYz2b80PM0IFhRuCE9Pnj0rcV-pTv93NhhdHODc8u0s0t2Kz4rBRRgoSyYDzz9f-vReU~~i47scKLg__&Key-Pair-Id=APKAIE5G5CRDK6RD3PGA)


This feature is available to Subscribers Only
Sign In or Create an Account Close Modal